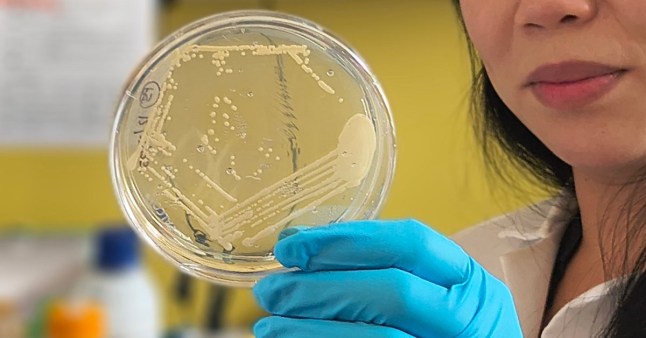
Study helps explain rare condition that causes the body to produce its own alcohol Picture: UC San Diego Health Sciences

People with the condition feel intoxicated, despite not drinking (Picture: Myles Goode/Getty Images)
If you’re ever outraged at how much a pint costs these days, we’ve got some news for you.
Auto-brewery syndrome (ABS) is a rare and often misunderstood condition that causes the body to produce its own alcohol.
While this might sound like a free night out, the gastrointestinal disorder can lead to memory loss, aggression and liver damage.
Now, researchers have identified a specific gut bacterium that appears to be driving alcohol production in patients with ABS.
A study published in Nature Microbiology yesterday saw scientists assess 22 people living with ABS and compared them to their 21 partners.
The University of California San Diego School of Medicine team discovered that ABS patients’ stool has more ethanol.
The condition was narrowed down to a group of tiny creatures living in guts (Picture: UC San Diego Health Sciences)
What is auto-brewery syndrome?
ABS has been studied for the better part of a century but scientists have struggled to explain it, with stigma and misdiagnosis rife.
People living with the conditions have been arrested of drunk-driving, while others have been accused of being secret alcoholics.
Also called gut fermentation syndrome, ABS sees fungi in the gut ferment carbohydrates like starchy or sugary foods into ethanol, effectively brewing alcohol inside the body.
Scientists have long been baffled by how the disorder can cause blood-alcohol levels in people that would be deadly if achieved through normal means.
The symptoms can be damaging, including cognitive impairment, digestive issues and withdrawal symptoms.
Only a few dozen people across the world have been diagnosed with ABS. Researchers stress, however, that the true number is likely higher.
Medicine professor Bernd Schnabl said: ‘We found that gut bacteria, including Escherichia coli and Klebsiella pneumoniae, ferment sugars into ethanol in the intestine in patients with ABS.
‘These microbes use several ethanol-producing pathways and drive blood-alcohol levels high enough to cause legal intoxication.’
Though some patients had different microbes wriggling in them, which were behind their ABS.
Antibiotics could be developed that target the enzymes involved in fermentation, the paper said.

Researchers also found better ways to diagnose ABS (Picture: UC San Diego Health Sciences)
Another could be faecal microbiota transplantation, where ‘poo donors’ see their beneficial gut microbes given to a patient.
One patient in the study was symptom-free for more than 16 months after two transplants.
Elizabeth Hohmann, another study author from Mass General Brigham Department of Medicine, added: ‘By determining the specific bacteria and microbial pathways responsible, our findings may lead the way toward easier diagnosis, better treatments, and an improved quality of life for individuals living with this rare condition.’
Stool tests could also be used as a better alternative method of diagnosis, blood-alcohol testing, the team recommended.
Get in touch with our news team by emailing us at webnews@metro.co.uk.
For more stories like this, check our news page.
Comments
Add Metro as a Preferred Source on Google
Add as preferred source
News Updates
Stay on top of the headlines with daily email updates.